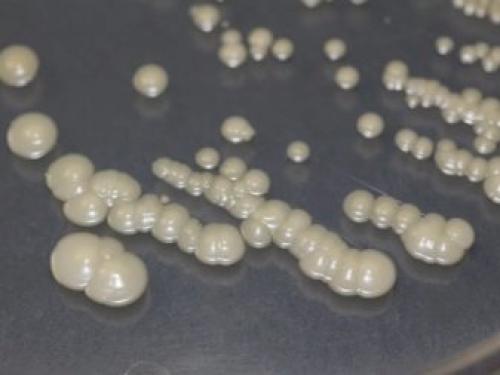
Как отличить настоящий жемчуг. Метод 1 Метод 1 из 4: Визуальная проверка 11 Как отличить настоящий жемчуг. Метод 1 Метод 1 из 4: Визуальная проверка 11

Как отличить настоящий жемчуг. Метод 1 Метод 1 из 4: Визуальная проверка
- Как отличить настоящий жемчуг. Метод 1 Метод 1 из 4: Визуальная проверка
- Как отличить культивированный жемчуг от искусственного. Как отличить настоящий жемчуг от искусственного
- Может ли жемчуг облезть. Как отличить настоящий жемчуг от искусственного
- Как выглядит настоящий жемчуг. Что нужно знать о натуральном жемчуге?
Как отличить настоящий жемчуг. Метод 1 Метод 1 из 4: Визуальная проверка
1
Обратите внимание на незначительные дефекты. Как сказано выше, настоящий жемчуг редко бывает идеальным . Как правило, у настоящего жемчуга не совсем правильная форма. X Источник информации aucoinhart.com/education/jewelry-education/pearls/determining-pearls-authenticity/ Помимо этого верхний слой жемчуга по-другому отражает свет на разные участки жемчужины. Искусственный жемчуг зачастую «чересчур идеальный». Он имеет идеальную сферическую форму, отличается блеском по всей поверхности и не имеет вмятин или других изъянов.
- Хотя идеально круглый жемчуг встречается довольно редко, но, тем не менее, он все-таки существует, ожерелья почти никогда не делают из такого жемчуга. Такие ожерелья, сделанные из идеально гладкого круглого жемчуга, скорей всего поддельные. X Источник информации
2
Проверьте, имеет ли жемчуг здоровый блеск. Блеском ювелиры называют отражение света на драгоценном камне. Блеск жемчужин – это именно то, что делает их такими красивыми. Качественный жемчуг имеет яркий чистый блеск, который появляется при попадании света на его поверхность. Если присмотреться, то вы увидите ваше собственное отражение на поверхности жемчуга. X Источник информации
- Эта проверка бывает неточной из-за того, что некачественный, но подлинный жемчуг (с неприметным бледным блеском) очень похож на поддельный. Поэтому сравнивайте результаты с результатами других проверок на подлинность, описанных в этой статье. X Источник информации
3
Обратите внимание на блики. Качественный жемчуг зачастую особенно ценится благодаря бликам, то есть не явно выраженным оттенкам, которые появляются при попадании света на внешней поверхности жемчуга. Искусственные жемчужины, как правило, не обладают таким эффектом, поэтому жемчуг так сложно подделать. Это означает, что, скорее всего, он настоящий, если кажется слегка затемненным под освещением. Розовый цвет и цвет слоновой кости – самые распространенные оттенки белого жемчуга, хотя существует множество других оттенков, например черный. X Источник информации
- Хотя цвет некоторых жемчужин определить довольно сложно, это не обязательно означает, что жемчуг поддельный.
4
Поищите признаки подлинности вокруг отверстия в жемчужине. Жемчуг на нитке или ожерелье зачастую имеет отверстие для продевания нитки. Осмотр этого отверстия поможет вам понять, настоящий ли жемчуг. Вот несколько важных аспектов, на которые следует обратить внимание: X Источник информации
- Четко очерченные края отверстия. Настоящий жемчуг, как правило, имеет отверстия с четко выраженными краями (наподобие полого цилиндра). Отверстия на фальшивом жемчуге обычно с грубыми и закругленными краями. При этом старые и поношенные, но все-таки настоящие жемчужины также имеют отверстия с закругленными краями. Отверстия на поддельном жемчуге зачастую выгнутые и не имеют идеальной цилиндрической формы. X Источник информации
- Отслоения краски или верхнего слоя вокруг отверстия. При трении жемчужин одна о другую вследствие продолжительного использования искусственный слой вокруг отверстия со временем изнашивается. В этом случае вы наверняка заметите осколки стекла или пластмассы под верхним слоем. Это верный признак подделки.
5
Загляните в отверстие, чтобы узнать, нет ли линии между внешним перламутровым слоем и ядром. Настоящий жемчуг почти всегда имеет чистый внешний перламутровый слой, в то время как фальшивый жемчуг зачастую имеет несколько тонких слоев искусственного перламутра или вообще не имеет таковых. Если в вашем жемчуге есть отверстие, вы можете проверить, нет ли в нем внутреннего перламутрового слоя, заглянув в него через увеличительное стекло. Настоящий жемчуг обычно (но не всегда) имеет ярко-выраженную линию, отделяющую верхний перламутровый слой от ядра (внутренней части жемчужины).
Как отличить культивированный жемчуг от искусственного. Как отличить настоящий жемчуг от искусственного

Ассортимент предлагаемый рынком
Романтичный ореол жемчуга делает его предметом желаний многих. Однако в природных условиях он растёт медленно, добывается тяжело, стоит запредельно. Люди научились выращивать прекрасные шарики самостоятельно. Поэтому стоит различать натуральный и культивированный материал. Самый доступный ценовой сегмент – из полимеров. Подробнее о видах, свойствах и кому подходит жемчуг мы писали здесь.
Натуральный
В природе существует два вида жемчужин: морские и речные. Первые дороже вторых в пять-шесть раз. Это неудивительно – чтобы найти одну качественную жемчужину, нужно вытащить из воды полтонны моллюсков. Пресноводный речной материал добывается легче, отличающие его признаки – не всегда идеальная форма и слабый блеск.
Морские жемчужины безупречных очертаний и блеска встречаются чаще на аукционах, чем в магазинах.
Культивированный
Подделкой не считается, хотя создаётся людьми. Технология следующая. На морской или речной ферме внутрь моллюска помещают основу-ядро. Созревание проходит в естественных условиях. Через два-три года получают жемчужину, визуально неотличимую от природной, но определённой формы и цвета. То есть перламутровый слой настоящий. Разница внутри: у культивированных экземпляров он нарастает вокруг искусственного ядра.
Толщина перламутрового покрытия зависит от срока создания жемчужины.
Качественные экземпляры поставляют с ферм побережья Индийского океана. Мировой лидер – Япония, далее идут Китай, Гонконг, Эмираты.
Поэтому приобретая культивированный жемчуг, узнавайте страну-производителя.
Искусственный
Продукт современных технологий. Фальшивые жемчужины бывают нескольких разновидностей.
Майорка
Процесс получения многоэтапный, поэтому имитация очень качественная. Как проверить подлинность жемчуга в этом случае, знает только эксперт. Названа по месту создания в испанском городе.
Римский
Бусинки из полого стекла с парафином внутри. Способ придуман в средневековье, первоначально представлял грубую работу. Позднее для покрытия использовали жемчужную эссенцию из чешуи рыб, что визуально облагородило такой искусственный жемчуг.
Shell pearl
Перламутровые ядра, покрытые лаком. Получена в 1920-е гг. в США.
Пластмасса
Откровенно низкокачественная продукция. Продаётся в отделах бижутерии.
10 тестов на подлинность жемчуга в домашних условиях
Имеются специальные тесты — как определить, натуральные это жемчужинки или подделка.
- Смотрят на края отверстий, просверленных в жемчужинах. У бусинок из стекла или пластмассы хорошо просматривается переход между ядрышком и перламутровыми слоями. При разрезании натурального камня что-либо рассмотреть очень сложно.
- Перламутровая поверхность у подлинной бусины — не идеально гладкая: она имеет неровности, ее цвет неоднороден, имеются более бледные и яркие пятнышки. Это из-за того, что на натуральной жемчужине, которая умещается в раковине, перламутр нарастает годами: в это время туда попадают небольшие песчинки, в результате поверхность становится неровной. У суррогата же — максимально ровный цвет.
- Если естественная жемчужина попадет ненадолго в огонь, с ней ничего не происходит, а вот стеклянная бусина трескается, пластиковая – начинает плавиться.
Жемчуг в уксусеРазрушительный тест
Чтобы определить, настоящий жемчуг или нет, необходимо взять бусинку и оставить ее в уксусе.- Если это классические подлинный камень, от него через какое-то время ничего не останется, он растворится.
- Если это натуральная “Майорка”, в итоге мы увидим только стеклянное ядрышко.
- Если же бусинка искусственная из стекла либо пластика, с ней ничего не случится.
Рентген
Если жемчужинки выглядят как настоящие, но вызывают сомнения, можно найти рентгеновский аппарат и положить в него одну бусинку.- Сделанный рентгеновский снимок покажет число слоев перламутра, плотность бусины, есть ли у нее ядро.
- Под аппарат кладут только один камешек, так как при облучении он может стать черным.
Проверка зубами
Чтобы проверить, настоящий ли жемчуг, его слегка трут о зубы.
- Если минерал — не поддельный, он скрипит и вызывает ощущение, что на зубах появился порошок. Это объясняется свойствами природного камня. Жемчуг довольно плотен, но у него невысокая твердость: 4 единицы по Моосу.
- К сожалению, способ не подходит для идентификации “Майорки”.
Проверка зубамиПроверка солнцем
Еще одна тонкость при определении натуральности жемчужин в домашних условиях — можно рассмотреть их под лучами солнца. Так удобнее проверять жемчуг на подлинность, например, на уличном рынке.
- Самородные перлы отсвечивают бледновато-голубым.
Распознаем подлинный жемчуг по формеОтличить поддельный жемчуг от настоящего также можно при помощи увеличительного стекла.Может ли жемчуг облезть. Как отличить настоящий жемчуг от искусственного
В наше время рынок драгоценных камней полон подделок и имитаций. И жемчужная промышленность не является исключением. Раньше жемчуг можно было найти только в дикой природе. Но из-за хищнической добычи он стал очень редким. На сегодняшний день технологии позволяют создавать искусственный жемчуг хорошего качества. А это означает, что вероятность покупки подделки высока.
Подделки со временем меняются. Искусственный жемчуг сегодня уже не имеет тех же характеристик, что и десять лет назад. Поэтому лучший способ определить натуральный жемчуг перед вами или нет, — это узнать его особенности.

Итак, давайте узнаем, как же определить, настоящую жемчужину.
Но сначала ответим на вопросы: «А что же такое жемчуг? И что значит пресноводный и культивированный?»
Жемчуг – это органическое образование, созданное моллюском. Он образуется как в соленой, так и в пресной воде. Природные жемчужины формируются внутри жемчужной устрицы или моллюска. Это происходит в результате попадания в раковину песчинки и возникающего вследствие этого раздражения.
Реагируя на раздражитель, моллюск окружает это место защитной тканью и заключает в некую капсулу из слоев перламутра. После этого на протяжении нескольких лет он продолжает откладывать слои перламутра. В итоге из тысяч тонких полупрозрачных пленок перламутра и формируется жемчужина.

Что значит пресноводный?
Пресноводный жемчуг — это жемчуг, который образуется естественным путем в пресной воде: в озерах, реках и прудах. Большинство пресноводных жемчужин белого цвета, но они могут иметь и различные оттенки: розовый, сиреневый и персиковый.
Что значит — культивированный жемчуг?
Культивированный жемчуг — это жемчуг, выращенный в настоящих устрицах на жемчужных фермах в Японии, Австралии, Индонезии, Китае и многих других местах. В отличие от природного культивированный жемчуг создан не естественным образом, а благодаря вмешательству человека.
На подводных жемчужных фермах культиваторы осторожно вставляют кусочки ткани мантии и семена перламутра или бусинки из ракушек в тело двустворчатых моллюсков. В качестве защитного механизма моллюск начинает выделять перламутр, который постепенно покрывает бусинку, позже образуя жемчужину. Состав и структура этого перламутра практически идентичны тому, который образуется естественным образом.

Советы, как отличить, настоящий жемчуг от подделки:
На ощупь
Первый и самый простой способ узнать, настоящий это жемчуг или нет, — это пощупать его. Когда вы касаетесь натурального жемчуга, он кажется прохладным и согревается при ношении. Искусственный на ощупь теплый и может быть липким при прикосновении к нему пальцами. Так же природный жемчуг имеет уникальный вес. Подделки могут быть слишком легкими или наоборот тяжелыми.
По форме
В природе не встречается двух абсолютно одинаковых жемчужин. Они будут отличаться по цвету, размеру и форме. Настоящий жемчуг будет разных размеров и форм, в отличие от подделок, которые в основном одинакового размера и формы .

Зубной тест
Аккуратно потрите жемчужину о передние зубы. Чувствуют ли они твердость или сопротивление? Если жемчуг натуральный или культивированный, вы почувствуете, что его поверхность песчанистая. Если он искусственный, то поверхность будет гладкой. Этого теста обычно достаточно, чтобы отличить даже лучшие подделки от настоящего жемчуга.
По трению
Вы можете потереть два жемчужины вместе. Если они настоящие, то вы испытаете легкое сопротивление. Когда одна жемчужина трется о другую, образуется жемчужная пудра. Тот же эффект можно увидеть, если слегка протереть их ножом. Если потереть подделки друг о друга, процесс будет гладким, и пудра не образуется.
Ударьте друг о друга двумя настоящими жемчужинами, и вы услышите мягкий и неповторимый звук. Когда поддельные бусины сбиваются вместе, звук получается очень слабым.

По блеску
Еще один способ узнать настоящий жемчуг — это проверить его блеск. Натуральный обладает уникальным жемчужным блеском и естественной шероховатостью. Это потому, что на его поверхности есть небольшие выступы. Эти гребни могут быть не видны невооруженным глазом. Однако специалисты и ювелиры могут проверить «естественные изъяны» жемчужины с помощью увеличительного стекла.
Так же настоящий жемчуг обладает способностью отражать свет, в отличие от имитаций, которые не имеют отражательной способности.
По отскоку
Отличный способ выявить подделку — это испытание на отскок. Бросьте жемчужину на стекло с высоты 60 см и наблюдайте за высотой отскока. Если жемчужина отскакивает более чем на 30 см, скорее всего, она настоящая, поскольку высота отскока искусственного жемчуга намного ниже.

С помощью лупы
Наблюдая за жемчугом под лупой, специалисты могут легко определить, является ли он подделкой или натуральный. Если его поверхность зернистая, то это натуральный самоцвет, а если текстура похожа на яичную скорлупу с шероховатой поверхностью, то это имитация.
Как выглядит настоящий жемчуг. Что нужно знать о натуральном жемчуге?
Украшения, сделанные из натурального жемчуга, относятся к категории люксовых и стоят дорого. Этот прекрасный камень подразделяется на несколько разновидностей , для каждой из которых характерны свои особенности.

Ознакомимся с ними.
- Морской жемчуг. Этот камень дивной красоты имеет идеальную округлую форму и отличается привлекательным блеском. Жизненный цикл этой красоты в среднем составляет 10 лет. В раковине камень созревает на протяжении нескольких лет. В одной ракушке может быть сформировано от 1 до 3 жемчужин.
Через небольшой временной промежуток морские камни начинают потихоньку терять свою яркость и характерный блеск, поскольку тонкий перламутровый слой начинает стираться. Окрас такого жемчуга бывает не только белым, но и более ярким, и даже грубоватым черным.
- Пресноводный. Жемчуг такого вида добывают из моллюсков, которые обитают в реках и озерах. Число камней перламутрового окраса в одной раковине может варьироваться от 12 до 16 штук. Они имеют более тусклый окрас, их блеск не бросается в глаза, являясь приглушенным. Форма такого жемчуга может сильно различаться.
Встречаются не только округлые, но и овальные варианты (именно они наиболее распространены). Эти камни устойчивы к истиранию, поскольку их перламутровый слой является более глубоким и плотным. Оттенок слоя чаще всего является молочным. Речной жемчуг не бывает розовым или черным.
Так как стоимость дикого жемчуга весьма значительна, в качестве альтернативного варианта может служить натуральный культивированный камень.